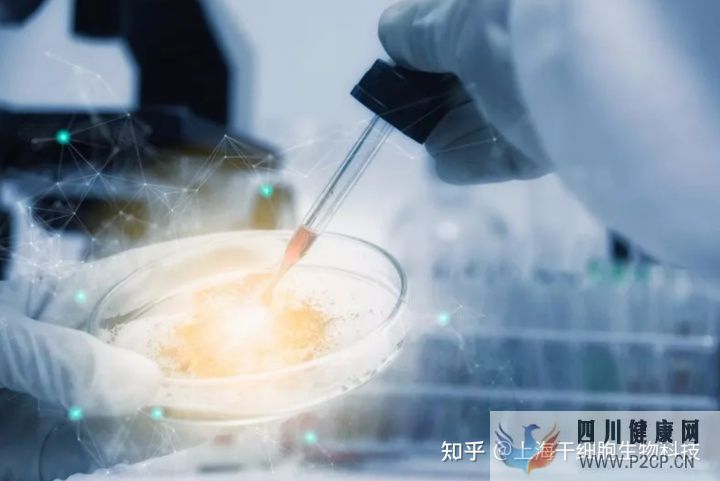
干细胞为什么被称为“全能ACE”,读这篇就够了(图3) 干细胞为什么被称为“全能ACE”,读这篇就够了(图3)

干细胞为什么被称为“全能ACE”,读这篇就够了
在我们身体的这个社会中,每一个细胞都经过专业“训练”各司其职,而干细胞还像是一张“白纸”,具有从事各种职业的潜能,比如修复损伤组织细胞、替代损伤细胞的功能或刺激机体自身细胞的再生功能等等,正因为这样的价值,在世界得到了广泛研发和讨论。


-那什么是干细胞呢?
干细胞是没有经过分化的细胞,也就是没有特殊功能的细胞。皮肤细胞可以保护身体,肌肉细胞可以收缩,神经细胞可以传递讯息;干细胞却没有任何特殊结构或功能,但干细胞有种潜力,就是变成人体中任何一种细胞。

简单来讲,干细胞是一类具有无限的或者永生的自我更新能力的细胞、能够产生至少一种类型的、高度分化的子代细胞。
干细胞初应用很多人觉得不现实可能就在于大家不是很了解,但韩国早在2011年就上市了一款治疗急性心梗的干细胞新药Hearticellgram-AMI。


2018年,南京鼓楼医院利用干细胞再生医学技术,改善卵巢血流,修复卵巢功能,使卵巢早衰患者成功生产。这是世界首例干细胞联合支架材料治疗卵巢早衰临床研究诞生的婴儿。
过去的人们普遍认为,以上这些干细胞一旦分化,便再也无法恢复干细胞状态。不过日本的 山中伸弥 教授在2006年打破了这个所谓的自然规律。他把小白鼠皮肤中的成纤维细胞(fibroblast)诱导为类似胚胎干细胞的多能干细胞。
这种诱导性多能干细胞(induced pluripotent stem cell。Ips cell)的问世意味着人体内高度分化的细胞也可以“逆转”为多能干细胞,由于临床治疗,补充天然干细胞来源的不足。
而且,使用这种干细胞不存在伦理道德方面的问题。山中伸弥 教授也因此技术摘取了2012年的诺贝尔生理学或医学奖。


诱导性多能干细胞虽然前途光明,但成本较高,安全性较低,成人体内的间充质干细胞(mesenchymal stem cell)可能更适用于干细胞疗法。成人体内的间充质干细胞属于多能干细胞,主要存在于人体的骨髓、脐带血和和脐带组织、胎盘组织和脂肪组织中。此外,在女性经血中也有它们的影踪。把这些干细胞收集起来,进行增殖和诱导,就能让它们分化为我们所需的不同细胞,比如肝细胞、心肌细胞、肌肉细胞、神经细胞等。
如果你对干细胞还有什么不够了解,欢迎一起探讨。
卫/星/号/xibao2050





